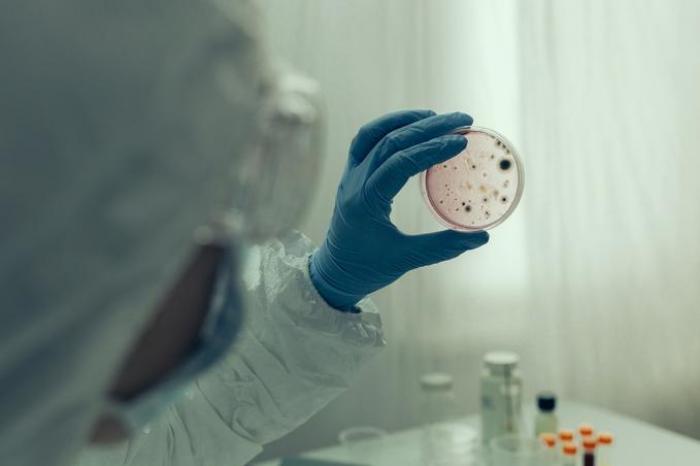
course-premium

Máster en epidemiología y salud pública (actualizado COVID-19)
-
He cursado en su institución y ha sido una muy buena experiencia. Los profesionales están continuamente apoyándote y resolviendo cada duda con fundamentos y de forma clara para que puedas avanzar de forma correcta. Estoy muy agradecida.
← | →
-
Estoy muy satisfecha con el curso. Debo destacar las tutorías, son realmente buenas, te despejan toda duda con criterio y de inmediato. Los temas de los cursos son muy completos y detallados, he reforzado mis conocimientos. Gracias por todo.
← | →
-
Estudiar en su centro ha sido una gran elección para mi futuro profesional. Los cursos que brindan son actualizados, innovadores y con un contenido formativo interesante y amplio. Recomiendo totalmente la institución a quienes busquen seriedad y confianza.
← | →
Master
Online

¿Necesitas un coach de formación?
Te ayudará a comparar y elegir el mejor curso para ti y a financiar tu matrícula en cómodos plazos.
¡Hazle frente al Covid-19!
-
Tipología
Master
-
Metodología
Online
-
Horas lectivas
750h
-
Duración
1 Año
-
Campus online
Sí
-
Servicio de consultas
Sí
-
Clases virtuales
Sí
¿Trabajas en el área de la salud y adquirir las competencias necesarias para hacer frente a los virus como el COVID 19? Pues, entonces esta formación que ha añadido a su catálogo Emagister es ideal para ti, se trata del Máster en epidemiología y salud pública, actualizado Covid-19, impartido por la prestigiosa Escuela Clínica y de Ciencias de la Salud, una completa formación que te prepara de la mejor manera para enfrentar los retos que se presentan en el día a día en esta área.
Mediante esta formación vas a conocer todo lo relacionado con la salud pública, las etapas de la enfermedad y los niveles de prevención, los determinantes e indicadores de salud, las políticas de salud, la organización del sistema sanitario y los tipos de centros sanitarios en el Sistema Sanitario Español. Además, conoces el concepto de demografía estática y dinámica, y profundizas tus conocimientos en epidemiología y promoción de la salud. Te pones al tanto de la información relevante acerca del Covid-19.
Este máster tiene una duración flexible, se desarrolla por medio del campus virtual en donde encuentras las clases y todo el contenido y el material de aprendizaje.
Si deseas ampliar tus conocimientos en el ámbito de la epidemiología, no dudes en sumarte a este máster que pone a tu alcance Emagister. Haz clic ahora en el botón “pide información”, deja tus datos para que un asesor pueda contactarte para darte más detalles y ayudarte con tu matriculación.
Información importante
Documentos
- CSA046.pdf
Precio a usuarios Emagister:
Instalaciones y fechas
Ubicación
Inicio
Inicio
A tener en cuenta
Permite conocer la epidemiología y la salud pública, políticas de salud y gestión de servicios sanitarios, demografía, la epidemiología en enfermedades infecciosas, en las patologías cardiovasculares, en el cáncer, en la obesidad, en la diabetes, en patologías respiratorias, la salud medioambiental, información relevante acerca de la COVID-19, como se propaga la COVID- 19, las medidas de protección e higiene ante la COVID-19.
El Máster en Epidemiología y Salud Pública está dirigido a personal médico y a todas aquellas personas que quieran ampliar sus conocimientos en relación con la epidemiología y salud pública.
No se necesitan requisitos previos.
Una vez finalizados los estudios y superadas las pruebas de evaluación, el alumno recibirá́ un diploma que certifica que ha finalizado con éxito el “Máster en epidemiología y salud pública (actualizado COVID-19)” de la Escuela clínica y de ciencias de la salud, avalada por la condición de socios de la CECAP. Además, recibirás el Certificado Universitario Internacional DQ, expedido por la Agencia Universitaria DQ vinculada con la UAIII y la Universidad CLEA, que incluye la equivalencia a créditos europeos (ECTS) sobre la carga horaria de tu formación.
En la modalidad online el alumno recibirá acceso a un curso inicial donde encontrará información sobre la metodología de aprendizaje, la titulación que recibirá, el funcionamiento del Campus Virtual, qué hacer una vez el alumno haya finalizado e información sobre la Escuela Clínica y de Ciencias de la Salud. Además, el alumno dispondrá de un servicio de clases en directo.
Un asesor va a estar contactando para brindarte toda la información.
Opiniones
-
He cursado en su institución y ha sido una muy buena experiencia. Los profesionales están continuamente apoyándote y resolviendo cada duda con fundamentos y de forma clara para que puedas avanzar de forma correcta. Estoy muy agradecida.
← | →
-
Estoy muy satisfecha con el curso. Debo destacar las tutorías, son realmente buenas, te despejan toda duda con criterio y de inmediato. Los temas de los cursos son muy completos y detallados, he reforzado mis conocimientos. Gracias por todo.
← | →
-
Estudiar en su centro ha sido una gran elección para mi futuro profesional. Los cursos que brindan son actualizados, innovadores y con un contenido formativo interesante y amplio. Recomiendo totalmente la institución a quienes busquen seriedad y confianza.
← | →
Valoración del curso
Lo recomiendan
Valoración del Centro
carla guillén
Diana Muñiz Gil
Juan José Morales
Raul Barrina
Laura Soler Moya
MARIANO MENESES SEIJO
LIDIA LAZARO BARBA
Logros de este Centro
Todos los cursos están actualizados
La valoración media es superior a 3,7
Más de 50 opiniones en los últimos 12 meses
Este centro lleva 5 años en Emagister.
Materias
- Vigilancia
- Diabetes
- Higiene
- Epidemiología
- Demografía
- Enfermedades infecciosas
- Enfermedades
- Políticas de salud
- Pública
- Etapas
- Concepto
Profesores
Equipo Docente de Grupo Tarraco
Docente
El equipo docente de Grupo Tarraco Formación está formado por profesionales en activo que combinan experiencia académica y práctica laboral. Su objetivo es guiar al estudiante en cada etapa del aprendizaje, ofreciendo asesoramiento continuo y resolviendo dudas de manera ágil para garantizar una formación aplicada y actualizada.
Temario
- Unidad Didáctica 1. Concepto De Salud
- Unidad Didáctica 2. Concepto De Enfermedad
- Unidad Didáctica 3. Necesidades Del Ser Humano
- Unidad Didáctica 4. Protección De La Salud
- Unidad Didáctica 1. Concepto De Salud Pública
- Unidad Didáctica 2. Evolución Histórica
- Unidad Didáctica 3. Funciones De La Salud Pública
- Unidad Didáctica 1. Nociones Básicas Sobre Ciencia Demográfica
- Unidad Didáctica 2. Herramientas De La Salud Pública
- Unidad Didáctica 1. Derecho A La Protección De La Salud
- Unidad Didáctica 2. Ley General De Sanidad
- Unidad Didáctica 3. Niveles Asistenciales
- Unidad Didáctica 4. Infraestructura Hospitalaria
- Unidad Didáctica 1. Concepto
- Unidad Didáctica 2. Enfoques En Epidemiología
- Unidad Didáctica 3. Clases De Estudios Epidemiológicos
- Unidad Didáctica 4. Etiología De Las Enfermedades
- Unidad Didáctica 1. Definición
- Unidad Didáctica 2. Tipos De Vigilancia
- Unidad Didáctica 3. Red Nacional De Vigilancia En España
- Unidad Didáctica 1. Concepto
- Unidad Didáctica 2. Cadena Epidemiológica
- Unidad Didáctica 3. Medidas De Prevención
- Unidad Didáctica 1. Definición
- Unidad Didáctica 2. Gripe
- Unidad Didáctica 3. Sars-Cov-2
- Unidad Didáctica 4. Medidas Preventivas
- Unidad Didáctica 1. Caracterización
- Unidad Didáctica 2. Medidas Preventivas
- Unidad Didáctica 1. Alteraciones Del Estado Nutricional
- Unidad Didáctica 2. Valoración Del Estado Nutricional
- Unidad Didáctica 3. Epidemiología Descriptiva De La Obesidad
- Unidad Didáctica 4. Medidas Preventivas
- Unidad Didáctica 1. Definición
- Unidad Didáctica 2. Técnicas De Diagnóstico
- Unidad Didáctica 3. Factores De Riesgo Y Medidas De Prevención
- Unidad Didáctica 1. Caracterización
- Unidad Didáctica 2. Vigilancia Epidemiológica Y Medidas De Prevención
- Unidad Didáctica 1. Aproximación Al Cáncer
- Unidad Didáctica 2. Tipos De Cáncer Más Frecuentes
- Unidad Didáctica 3. Diagnóstico Y Prevención
- Unidad Didáctica 1. Concepto De Medioambiente
- Unidad Didáctica 2. Indicadores Ambientales
- Unidad Didáctica 3. Estrategia Europea De Salud Ambiental
- Unidad Didáctica 1. Nociones Básicas
- Unidad Didáctica 2. Educación Sanitaria
- Unidad Didáctica 3. Vacunación
Información adicional
¿Necesitas un coach de formación?
Te ayudará a comparar y elegir el mejor curso para ti y a financiar tu matrícula en cómodos plazos.
Máster en epidemiología y salud pública (actualizado COVID-19)






